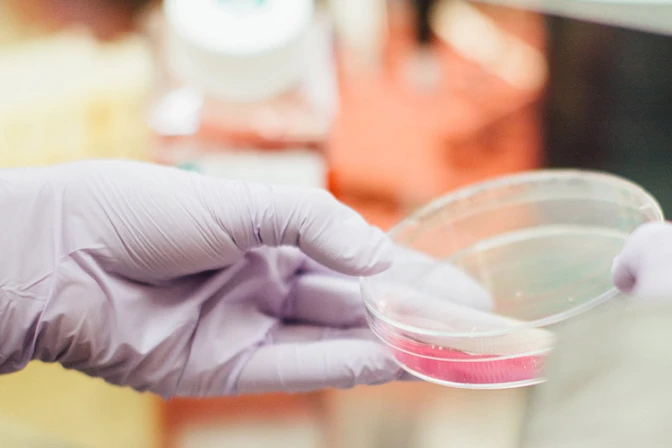

El Gobierno de Estados Unidos anunció que dejará de financiar las investigaciones con cuerpos de bebés abortados que eran realizadas para el Estado por la Universidad de California (UCLA) en San Francisco.
La decisión, anunciada el 5 de junio, sigue a una "revisión exhaustiva" por parte del Departamento de Salud y Servicios Sociales de los Estados Unidos (HHS), anunciada en septiembre de 2018, sobre cualquier investigación relacionada con tejido fetal.
Recibe las principales noticias de ACI Prensa por WhatsApp y Telegram
Cada vez es más difícil ver noticias católicas en las redes sociales. Suscríbete a nuestros canales gratuitos hoy:
La revisión se propuso encontrar "alternativas adecuadas" para evitar el uso del tejido fetal humano totalidad. En ese momento, el HHS prometió "garantizar que los esfuerzos para desarrollar tales alternativas sean financiados y acelerados".
La revisión identificó un programa en la Universidad de California, San Francisco, que utilizaba tejido fetal, y se tomó la decisión de no renovar su contrato con fondos federales. La no renovación significa que los Institutos Nacionales para la Salud (NIH) ya no financian ninguna investigación que involucre restos de bebés abortados.
El programa de investigación incluyó el uso de médula ósea, timos e hígados que se utilizaron para crear ratones con sistemas inmunitarios similares a los humanos. Los "ratones humanizados" se utilizaron para diversas pruebas y experimentos.
El congresista Chris Smith calificó el cierre del programa como "un paso importante para detener la práctica bárbara de usar las partes del cuerpo de los bebés abortados para la investigación".
En un comunicado, Smith calificó la práctica de utilizar los tejidos fetales como "no éticos" e "ineficaces", alegando que no ha producido "un solo tratamiento clínico".
Smith dijo además que existen otras técnicas que no involucran el uso de ninguna parte del cuerpo fetal que son "alternativas éticas probadas para esta investigación que puede salvar vidas".
El anuncio se produce solo un día después de que los miembros de la Cámara de Representantes empezaron a trabajar para evitar la financiación federal de otras polémicas investigaciones.
Desde 2016, el proyecto de ley de asignaciones contiene un anexo que prohíbe a la Administración Federal de Alimentos y Medicamentos (FDA, por sus siglas en inglés) y a los NIH realizar investigaciones o financiar pruebas que incluyan la edición genética de embriones o líneas germinales humanas.
El anexo se retiró de un borrador del proyecto de ley de presupuesto de 2020, pero la comisión presupuestaria de la Cámara de Representantes aprobó una enmienda el martes 4 de junio para restablecer aquel lenguaje.
El congresista Jeff Fortenberry, miembro destacado del subcomité de agricultura, habló en la reunión del comisión presupuestaria del martes a favor de mantener la prohibición de la edición de genes embrionarios.
Fortenberry dijo que la experimentación genética humana está cargada de preguntas éticas en gran medida no abordadas por los investigadores, y que el financiamiento de investigaciones desconocidas podría eliminar tratamientos efectivos.
"Si cedemos este marco de la ciencia y la ética a los bioingenieros disidentes que se desprenden de consideraciones sociales más amplias, los riesgos de daño son reales, y desviaremos estos recursos de las alternativas reales y viables", dijo Fortenberry.
Traducido y adaptado por Diego López Marina. Publicado originalmente en CNA.